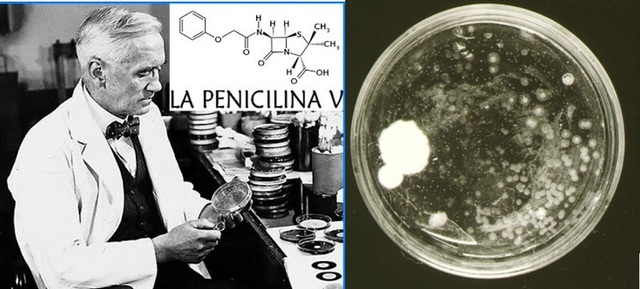
Alexander Fleming

-
Presentación de la teoría de las cadenas laterales para explicar la formación de anticuerpos
-
descubre anticuerpos en la sangre de animales inmunizados.
-
Demuestran que la Espiroqueta Treponema Pallidum es el agente productor de la sífilis
-
Acuñó el término inmunoquímica para referirse a la unión de la química con la inmunología biomédica. Aplicó la inmunoquímica en el estudio de los anticuerpos.
-
Demostraron que los polisacáridos del neumococo son antígenos.
-
Diseña el primer microscopio electrónico
-
lleva a cabo el descubrimiento de la transformación bacteriana.
-
Descubre el primer antibiótico, la penicilina penicillium nonatum.
-
desarrolla el primer microscopio electrónico de transmisión
-
Consigue cristalizar el virus del mosaico del tabaco (que permaneció activo después de la cristalización).
-
Llevaron a cabo una serie de experimentos con células bacterianas y virus, llamado test de fluctuación, demostrando que en las bacterias, las mutaciones genéticas se producen en ausencia de selección.
-
Descubre la Estreptomicina. Aisló dos cepas de actinobacteria, que podían efectivamente detener el crecimiento de ciertas bacterias resistentes a la penicilina, la E. Coli y el bacilo de Koch, causante de la tuberculosis.
-
Descubren que el DNA es material genético.
-
Demuestran la existencia de conjugación en Escherichia Coli.
-
El descubrimiento de la doble hélice, la estructura retorcida de escalera del ácido desoxirribonucleico ADN
-
Descubrieron la estructura de las inmunoglobulinas ( estructura química exacta de un anticuerpo)
-
Emitió la teoría de la selección clonal para explicar la síntesis de anticuerpos.
-
Descubren que el codón UUU codificaba para el aminoácido fenilalanina, experimento que sentó las bases para la elucidación del código genético.
-
Descubrió el virus del Ébola
-
Reconocen las archeas como el tercer dominio de los seres vivos.
-
Aislan e identifican el virus de la inmunodeficiencia humana (VIH, SIDA).
-
Desarrollan un Árbol filogenético basado en datos del ARNr, mostrando la separación de bacterias, arqueas y eucariontes.
-
Desarrollan un “ichip” (isolation chip, cápsula de aislamiento),de plástico, que permite masificar el proceso para el cultivo de bacterias.
Looking for a timeline maker?
Create timelines for projects, roadmaps, history, lessons, legal cases, and stories with Timetoast. Timetoast is a timeline maker for work, school, research, and stories.